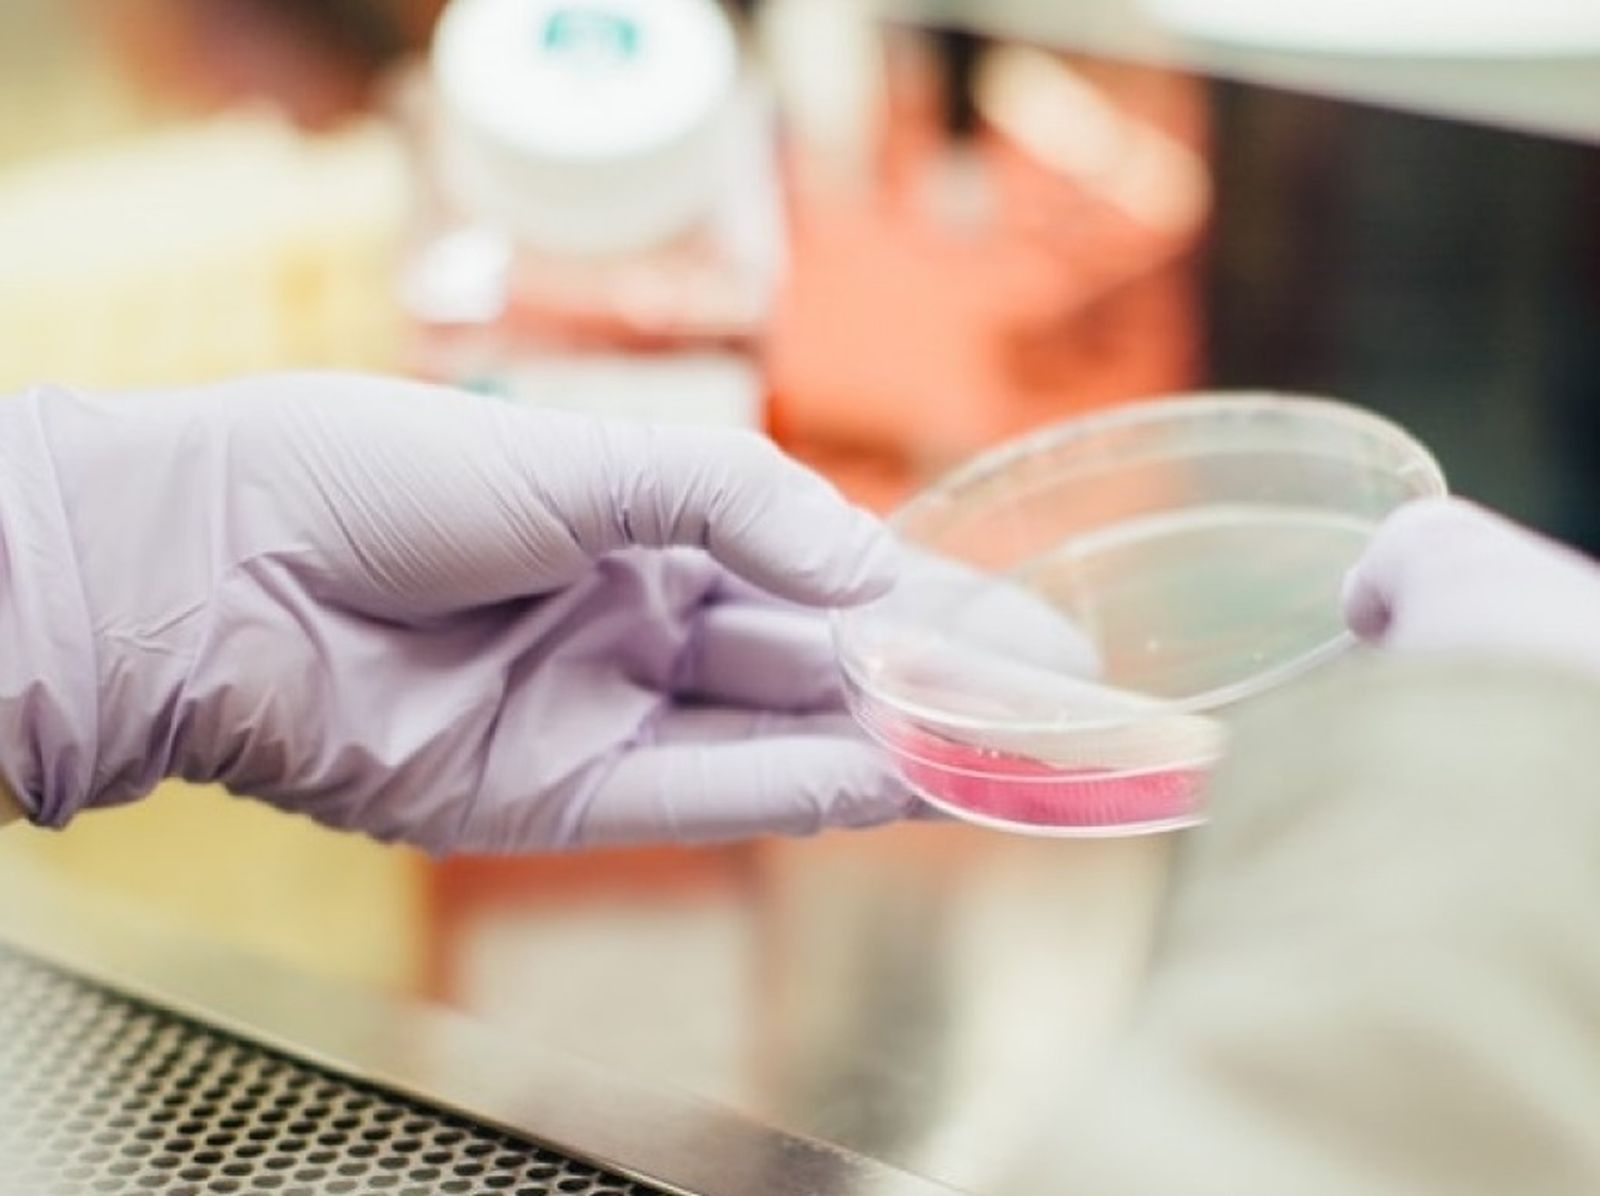
Ensayo en un laboratorio.

La UCO ensaya un nuevo fármaco para mejorar la fertilidad de mujeres con ovario poliquístico
Investigación
El trabajo cuenta con investigadores del Imibic y de la biotecnológica Oxfolife
El grupo de investigación Balance Energético, Pubertad y Salud Reproductiva de la Universidad de Córdoba (UCO) y el Instituto Maimónides de Investigación Biomédica (Imibic), junto a Oxolife, la biotecnológica con sede en Barcelona, desarrollan un proyecto para dar una solución a las mujeres con infertilidad asociada al ovario poliquístico.
No en vano, se estima que una de cada diez mujeres en edad fértil sufre el síndrome de ovario poliquístico. la prevalencia de mujeres con este síndrome a nivel mundial se estima alrededor de 150 millones de mujeres, un 80% de las cuales tienen asociados cuadros de infertilidad. La sintomatología de cada mujer puede ser muy variable. Mientras que en casos más leves el ovario poliquístico está acompañado de irregularidades en la menstruación y algo de acné, hay manifestaciones más severas que se asocian a resistencia insulínica, obesidad o infertilidad
El grupo UCO-Imibic focaliza su investigación en el estudio de la sintomatología y el desarrollo terapias dirigidas y personalizadas frente al síndrome de ovario poliquístico, con el desarrollo de modelos únicos para avanzar en la comprensión del este complejo síndrome.
Por su parte, Oxolife desarrolla OXO-001, una molécula que actúa sobre la implantación embrionaria, preparando el endometrio para que el embrión se establezca y así aumentar las tasas de éxito de embarazo.
Adicionalmente en los primeros ensayos de OXO-001 (fase preclínica) se detectó que el fármaco mejoraba hasta en un 80% la fertilidad de un modelo con características de ovario poliquístico. De esta manera, Oxolife decidió abrir una nueva línea de investigación para conocer la eficacia de su fármaco en ovario poliquístico.
Para llevar a cabo esta vía de investigación son necesarios el uso de modelos animales de ovario poliquístico caracterizados y tecnologías específicas. Para el doctor José María Canals, de Oxolife, "establecer la colaboración con el Imibic, centro pionero en el estudio y desarrollo de modelos con síndrome del ovario poliquístico a nivel mundial, es un paso natural para nuestra estrategia de I+D”.
Con este acuerdo, la compañía inicia una colaboración con un grupo de investigación que ya tiene experiencia y conocimiento amplio sobre el ovario poliquístico y diferentes modelos desarrollados teniendo en cuenta los diferentes aspectos que presenta esta enfermedad. Así, se obtiene también una perspectiva de aplicabilidad de sus actividades, más encuadradas en la ciencia básica.
El fármaco, que ha testado con éxito su bioseguridad, podría ser una de las soluciones a las problemáticas de infertilidad en general y para mujeres con ovario poliquístico en concreto.
El acuerdo de colaboración establecido por ambas entidades está parcialmente financiado por la convocatoria de Proyectos de I+D+i Retos – Colaboración del Plan Estatal de Investigación Científica y Técnica y de la Innovación 2017 – 2020.
También te puede interesar
Lo último








